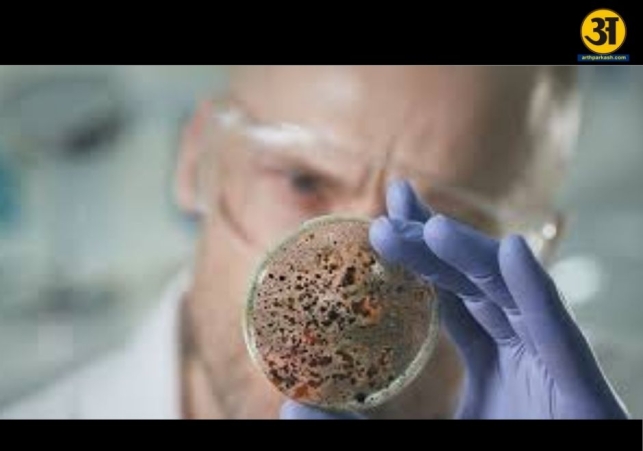
Doctors warn of rising fungal infections misdiagnosed as bacterial pneumonia

Fungal pneumonia often mistaken for bacterial infection, say experts
Doctors warn of rising fungal infections misdiagnosed as bacterial pneumonia
When someone catches pneumonia, doctors usually prescribe antibiotics right away. This is because in most cases, pneumonia is caused by bacteria, and antibiotics help clear the infection. Most patients start feeling better within a week or two. But sometimes, even after several rounds of medication, the illness refuses to go away. That’s when doctors start to suspect that the pneumonia might not be bacterial at all.
According to Dr. Neha Mishra, Consultant of Infectious Diseases at Manipal Hospital, Bengaluru, a few patients who do not improve despite proper antibiotic treatment may actually have fungal pneumonia. “A subset of patients who do not respond to antibiotics needs further investigation,” she explains. “This non-response often points to another cause, most commonly a fungal infection.”
Fungal pneumonia is quite different from bacterial or viral types and is not contagious. It happens when fungal spores from the environment enter the lungs. These spores are usually found in soil, decaying leaves, or construction dust. Most healthy people can fight off these spores naturally, but those with weak immunity may not.
People with conditions such as diabetes, cancer, chronic lung disease, or those taking steroids or immunosuppressants for long periods are more likely to develop fungal pneumonia. Their immune systems are not strong enough to destroy the fungi, allowing them to grow and infect the lungs.
The fungi most often responsible include Aspergillus, Histoplasma, and Mucor species. The symptoms—fever, cough, chest pain, and shortness of breath—are almost identical to bacterial pneumonia. Because of this similarity, many fungal infections go unnoticed for weeks, sometimes until the infection becomes severe or spreads to other organs.
The real reason antibiotics fail
When pneumonia does not improve after antibiotics, it’s a sign that the infection may not be bacterial. Dr. Mishra says that such cases “must not be mistaken for slow recovery.” Continuing to take antibiotics in this situation can do more harm than good because it delays the correct diagnosis and the proper treatment.
Doctors then turn to advanced diagnostic tests to find the real cause. These may include molecular testing, fungal culture, and biomarker analysis to detect the presence of fungal elements in the body. These tests are important because fungal pneumonia requires antifungal medicines, not antibiotics.
The treatment depends on the type of fungus and how much of the lung it has affected. Common antifungal drugs include voriconazole, amphotericin B, and posaconazole, among others. However, Dr. Mishra warns that antifungal medicines must be used carefully since they can affect the liver and kidneys or interfere with other medications. Patients should take them under strict medical supervision only.
“Those with weak immune systems should be closely monitored,” Dr. Mishra advises. “An early and correct diagnosis, followed by the right antifungal therapy, can greatly reduce the chances of complications and improve recovery.”
Fortunately, when detected early, fungal pneumonia is treatable. But delayed treatment can be life-threatening. The fungus may spread beyond the lungs to the brain, kidneys, or heart, making it much harder to control.
ALSO READ: Delhi’s winter pollution may lower your body’s natural defenses, say doctors
ALSO READ: The AI boom: innovation surge or bubble waiting to burst?
Why greater awareness is important
Fungal pneumonia is becoming a growing concern around the world. As more people are receiving immunosuppressant treatments for illnesses like cancer, autoimmune diseases, or organ transplants, their risk of fungal infections is also increasing. Climate change and construction dust are adding to the problem by spreading more spores into the air.
Dr. Mishra says awareness among both doctors and patients is crucial. Many people continue to take repeated courses of antibiotics when pneumonia lingers, believing it will eventually work. But this approach only delays recovery. “If your pneumonia doesn’t improve even after proper antibiotic treatment, don’t ignore it,” she says. “You should consult a specialist for further tests.”
Simple awareness can make a huge difference. Recognising that not all pneumonia is bacterial can help people get the right diagnosis sooner. Warning signs such as fever that doesn’t subside, persistent cough, or breathing difficulty despite taking medicines should never be ignored.
As Dr. Mishra notes, “Fungal pneumonia is not as rare as we once thought. It’s rising quietly and needs timely attention. Greater awareness, early diagnosis, and correct antifungal therapy can save lives.”
Ultimately, when antibiotics fail to work, it doesn’t always mean the infection is resistant — it might mean it’s something else entirely. Understanding that difference can lead to faster recovery, better outcomes, and, most importantly, saved lives.





